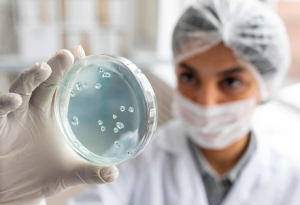
Identificação e Seleção de microrganismos de alto desempenho para expressão de proteínas para fins alimenticios

Alimentos e Bebidas e Biotecnologia Industrial



Soluções Inteligentes para o Setor de Alimentos, Bebidas e Biotecnologia Industrial
O SENAI CIMATEC oferece soluções inovadoras para o setor de alimentos e bebidas, com foco no desenvolvimento de processos de produção, controle de qualidade e embalagem. Nosso suporte abrange desde pesquisas sobre novos ingredientes até o aprimoramento da otimização de processos fabris, garantindo sempre a segurança alimentar como prioridade em todas as etapas.

Microencapsulamento de Nutrientes
Microbiologia Industrial
Desenvolver sistemas de microencapsulamento de ativos nutricionais e tecnológicos, incluindo nutrientes, compostos bioativos e aditivos, com o objetivo de proteger, estabilizar e controlar a liberação desses ingredientes em alimentos, suplementos e rações. Atuar com diferentes técnicas e materiais encapsulantes, otimizando a biodisponibilidade, a estabilidade físico-química e a funcionalidade em aplicação humana e animal.

Ração Animal
Microbiologia Industrial
Desenvolver produtos alimentícios destinados à nutrição animal, com foco na formulação, caracterização e avaliação tecnológica de ingredientes e aditivos aplicáveis a rações, petiscos e suplementos. Atuar no desenvolvimento de soluções inovadoras, sustentáveis e compatíveis com exigências produtivas, contando com o apoio técnico de áreas especializadas para validações zootécnicas.

Plant-Based/Cell-Based
Microbiologia Industrial
Desenvolvimento de produtos alimentícios cell-based e plant-based, com base em tendências de mercado, viabilidade técnico-científica, aspectos regulatórios, parâmetros de segurança alimentar e potencial de escalabilidade. Entregar soluções alimentares inovadoras, sustentáveis e tecnicamente viáveis, com foco em proteínas alternativas

Estudo do consumidor para aceitação de novos produtos (Escalas de atitudes)
Microbiologia Industrial
Interpretar e validar como os consumidores percecionam, avaliam e demonstram predisposição para aceitar um novo produto. O estudo pode ter o foco foco em qualidade, desenvolvimento de produtos e preferências do consumidor. O objetivo é medir a perceção do consumidor sobre características do produto (qualidade, utilidade, inovação, sabor, design, etc.); a atitude global em relação ao produto (gosto, preferência, interesse); a intenção de compra ou adoção; possíveis barreiras ou rejeições.
Este tipo de estudo ajuda as organizações a prever o sucesso de um novo produto no mercado e a ajustar características antes do lançamento.
Identificação e Seleção de microrganismos de alto desempenho para expressão de proteínas para fins alimenticios
Microbiologia Industrial

Desenvolvimento de extratos e compostos naturais do bioma brasileiro;
Microbiologia Industrial
Pesquisar, desenvolver e aplicar rotas tecnológicas inovadoras para a obtenção, modificação ou aproveitamento de ingredientes e resíduos agroindustriais, visando a agregação de valor, funcionalidade, sustentabilidade e viabilidade técnica. Desenvolvimento de novos produtos com base em ingredientes alternativos, considerando critérios de rendimento, pureza, estabilidade, escalabilidade e conformidade regulatória).

Aplicação de enzimas para melhoria de processos
Microbiologia Industrial

Desenvolvimento de rotas biotecnológicas para tratamento de rejeitos e resíduos
Microbiologia Industrial

Bioprospecção de microrganismos e moléculas geral e/ou de alto valor agregado a partir de resíduos industriais
Microbiologia Industrial

Auditorias em Segurança do Alimento
Microbiologia Industrial
Processo sistemático de avaliação realizado para verificar se uma empresa cumpre as normas de segurança do alimento (incluindo: higiene, qualidade e legislação aplicável). Envolve a análise de procedimentos, instalações, práticas de manipulação, documentação e registos, com o objetivo de identificar conformidades e não conformidades.
O intuito principal é garantir que os alimentos produzidos, manipulados ou distribuídos são seguros para consumo e cumprem os requisitos legais e normativos.
Explore as principais tendências em ciência, tecnologia e Inovação. Aqui, você encontrará conteúdos sobre o futuro da indústria e o impacto das novas tecnologias.

Por Prof. Dr. Willams Barbosa; Profa. Dra. Josiane Dantas; Eduardo Peres, estudante – Universidade SENAI...

Por Prof. Dr. Erick Sperandio, professor de IA da Universidade SENAI CIMATEC e da University...

Durante os dois dias de programação, os especialistas compartilharam seus conhecimentos por meio de palestras...
Saiba Mais
Para saber mais sobre como atuamos no seu segmento, entre em contato conosco e agende uma visita
Você pode escolher quais categorias de cookies deseja permitir. As categorias não essenciais ficam desativadas por padrão e só serão utilizadas mediante seu consentimento. Você pode alterar essas preferências quando quiser.